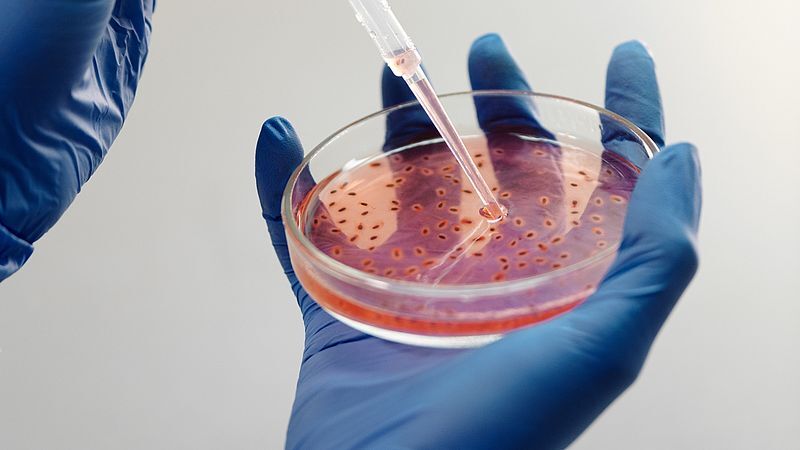
سلول های بنیادی بهتر از دارو بیماری ام اس را کُند می کند سلول های بنیادی بهتر از دارو بیماری ام اس را کُند می کند

به گزارش سلامت نیوز به نقل از مهر از مدیسن نت، این تحقیق آخرین نگاه به یک درمان جایگزین بالقوه برای برخی از بیماران مبتلا به ام اس است که با استفاده از سلولهای بنیادی خون فرد برای راه اندازی مجدد سیستم ایمنی معیوب او انجام میشود.
مطالعات نشان داده اند که این رویکرد ممکن است برای برخی از بیماران در مراحل اولیه ام اس مفید باشد. اکنون، یافتههای جدید نشان میدهد که همین امر میتواند در مورد برخی از بیماران در مرحله دوم بیماری که به عنوان MS پیشرونده ثانویه شناخته میشود، صادق باشد.
محققان دریافتند که در میان بیش از ۲۰۰۰ بزرگسال ایتالیایی مبتلا به ام اس پیشرونده ثانویه، افرادی که تحت درمان با سلولهای بنیادی قرار گرفتند، در طول ۵ سال بهتر از افرادی که از داروهای استاندارد استفاده میکردند، عمل کردند.
در مجموع، ۶۲ درصد در مقایسه با ۴۶ درصد از بیمارانی که دارو مصرف میکردند، وضعیت شأن وخیمتر نشده بود. تعداد کمی – ۱۹ درصد - در مقایسه با ۴ درصد گروه دارو حتی در طول پنج سال بهبود یافتند.
کارشناسان گفتند که این یافتهها به شواهدی مبنی بر نویدبخش بودن رویکرد سلولهای بنیادی میافزاید.

نظر شما